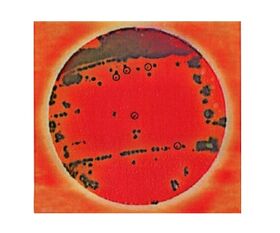

説明
【特徴】
●低夾雑菌(<10^4CFU/g)の検体は選択増菌培養が不要です。
●乾式フィルム状のできあがり培地です。
●選択分離培養が1枚でできます。
●プレートに含まれる指示薬でコロニーの識別を容易にします。
●保管および培養時のスペースを取らず、使用後の廃棄も容易です。
●AOAC intl.OMA認証取得
●※「食品衛生検査指針 微生物編2018」収載製品
【仕様】
●培養温度:41.5±1℃
●培養時間:24±2時間
●入数:1箱(25枚/袋×2袋入)
●※保存方法:2~8℃
●★旧メーカーJANコード:0707387765828
追加情報
メーカー名:
ネオジェンジャパン
メーカー品番:
6536SALX
予定納期:
注文から1~3日で発送